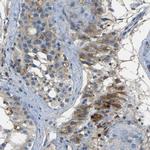
NETO2 Antibody in Immunohistochemistry (Paraffin) (IHC (P))

Search
Invitrogen
NETO2 Polyclonal Antibody
{{$productOrderCtrl.translations['antibody.pdp.commerceCard.promotion.promotions']}}
{{$productOrderCtrl.translations['antibody.pdp.commerceCard.promotion.viewpromo']}}
{{$productOrderCtrl.translations['antibody.pdp.commerceCard.promotion.promocode']}}: {{promo.promoCode}} {{promo.promoTitle}} {{promo.promoDescription}}. {{$productOrderCtrl.translations['antibody.pdp.commerceCard.promotion.learnmore']}}
产品信息
PA5-53029
种属反应
宿主/亚型
分类
类型
抗原
偶联物
形式
浓度
规格
纯化类型
保存液
内含物
保存条件
运输条件
RRID
产品详细信息
Immunogen sequence: SYPPNKECIY ILEAAPRQRI ELTFDEHYYI EPSFECRFDH LEVRDGPFGF SPLIDRYCGV KSPPLIRSTG RFMWIKFSSD EELEGLGFRA KYSFIPDPDF TYLGGILNPI PDCQFELSGA DGIVRSSQVE QEEKTKPGQA VDCIWTIKA
Highest antigen sequence identity to the following orthologs: Mouse - 97%, Rat - 98%.
靶标信息
NETO2 is a predicted transmembrane protein containing two extracellular CUB domains followed by a low-density lipoprotein class A (LDLa) domain. It also has an intracellular FXNPXY-like motif, which has been shown in other proteins to be essential for the internalization of clathrin coated pits during endocytosis.This gene encodes a predicted transmembrane protein containing two extracellular CUB domains followed by a low-density lipoprotein class A (LDLa) domain. It also has an intracellular FXNPXY-like motif, which has been shown in other proteins to be essential for the internalization of clathrin coated pits during endocytosis. Alternatively spliced transcript variants have been observed, but they have not been fully characterized.
仅用于科研。不用于诊断过程。未经明确授权不得转售。
篇参考文献 (0)
生物信息学
蛋白别名: Brain-specific transmembrane protein containing 2 CUB and 1 LDL-receptor class A domains protein 2; FLJ10430; FLJ14724; FLJ90456; NEOT2FLJ14724; NETO2; neuropilin (NRP) and tolloid (TLL)-like 2; Neuropilin and tolloid-like protein 2; unnamed protein product
基因别名: BTCL2; NEOT2; NETO2; UNQ1926/PRO4401
UniProt ID: (Human) Q8NC67
Entrez Gene ID: (Human) 81831